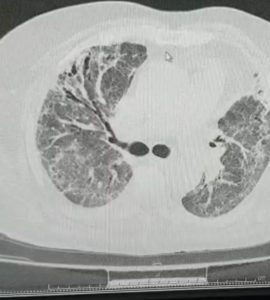

Acest website foloseste atât cookie-uri proprii, cât şi de la terţi, pentru a furniza vizitatorilor o experienţă mult mai bună de navigare şi servicii adaptate nevoilor şi interesului fiecăruia.
În conformitate cu Directiva „e-Intimitate” a UE, în vigoare de la 26 mai 2012 şi cu prevederile Legii nr. 506 din 17 noiembrie 2004 privind prelucrarea datelor cu caracter personal şi protecţia vieţii private în sectorul comunicaţiilor electronice, tuturor vizitatorilor website-ului li se cere consimţământul înaintea transmiterii de cookies în computerele acestora.
Ce este un „cookie”?
Un „Internet Cookie” (termen cunoscut şi ca „browser cookie”, „HTTP cookie” sau pur şi simplu „cookie”) este un fişier de mici dimensiuni, format din litere şi cifre, care va fi stocat pe computerul, terminalul mobil sau alte echipamente ale unui utilizator de pe care se accesează Internetul. Cookie-ul este instalat prin solicitarea emisă de către un web-server unui browser (ex: Internet Explorer, Chrome) şi este complet „pasiv” (nu contine programe software, virusi sau spyware si nu poate accesa informatiile de pe hard driveul utilizatorului).
Scopul și utilizarea modulelor cookie
Site-ul Autorităţii Naţionale pentru Persoanele cu Dizabilităţi instalează module cookie doar pentru a permite îmbunătățirea funcțiilor oferite, astfel încât experiența ocazionată de vizitarea site-ului să devină mai plăcută. Autoritatea Naţională pentru Persoanele cu Dizabilităţi nu utilizează module cookie pentru a culege, a prelucra, a difuza sau a înregistra date cu caracter personal.
„Cookie”-urile joacă un rol important în facilitarea accesului şi livrării multiplelor servicii de care utilizatorul se bucură pe Internet, cum ar fi:
• Personalizarea anumitor setări precum:
– limba în care este vizualizat un site;
– moneda în care se exprimă anumite preţuri sau tarife;
– păstrarea opţiunilor pentru diverse produse (măsuri, alte detalii etc.) în coşul de cumpărături (şi memorarea acestor opţiuni) – generându-se astfel flexibilitatea „coşului de cumpărături”;
– accesarea preferinţelor vechi prin accesarea butonului „Înainte” şi „Înapoi”.
• Cookie-urile oferă deţinatorilor de site-uri feedback asupra modului cum sunt utilizate site-urile lor de către utilizatori, astfel încât să le poată face şi mai eficiente şi mai accesibile pentru utilizatori;
• Permit aplicaţiilor multimedia sau de alt tip de pe alte site-uri să fie incluse într-un anumit site pentru a crea o experienţă de navigare mai valoroasă, mai utilă şi mai placută;
• Îmbunătăţesc eficienţa publicităţii online.
Care sunt avantajele cookie-urilor?
Un cookie conţine informaţii care fac legătura între un web-browser (utilizator) şi un web-server anume (website-ul). Dacă un browser accesează acel web-server din nou, acesta poate citi informaţia deja stocată şi reacţiona în consecinţă. Cookie-urile asigură utilizatorilor o experienţă plăcută de navigare şi susţin eforturile multor website-uri pentru a oferi servicii confortabile utilizatorilor: ex – preferinţele în materie de confidenţialitate online, opţiunile privind limba site-ului, coşuri de cumpărături sau publicitate relevantă.
Care este durata de viaţă a unui cookie?
Cookie-urile sunt administrate de webservere. Durata de viaţă a unui cookie poate varia semnificativ, depinzând de scopul pentru care este plasat. Unele cookie-uri sunt folosite exclusiv pentru o singură sesiune (session cookies) şi nu mai sunt reţinute, odată ce utilizatorul a părăsit website-ul, în timp ce alte cookie-uri sunt reţinute şi refolosite de fiecare dată când utilizatorul revine pe acel website (‘cookie-uri persistente’). Cu toate acestea, cookie-urile pot fi şterse de un utilizator în orice moment prin intermediul setărilor browserului.
Ce sunt cookie-urile plasate de terţi?
Anumite secţiuni de conţinut de pe unele site-uri pot fi furnizate prin intermediul unor terţe părţi / furnizori (ex.: news-box, un video sau o reclamă). Aceste terţe părţi pot plasa cookie-uri prin intermediul altui website şi ele se numesc „third party cookies” pentru că nu sunt plasate de proprietarul website-ului respectiv. Furnizorii terţi trebuie să respecte de asemenea legea în vigoare şi politicile de confidenţialitate ale deţinătorului site-ului.
Aceste cookie-uri pot proveni de la următorii terţi: facebook.com, twitter.com, etc.
Cum sunt folosite cookie-urile de către website
O vizită pe website poate plasa cookie-uri în scopuri de:
Alte cookie-uri ale terţelor părţi
Pe unele pagini, terţii pot seta propriile cookie-uri anonime, în scopul de a urmări succesul unei aplicaţii sau pentru a particulariza o aplicaţie. Datorită modului de utilizare, website-ul nu poate accesa aceste cookie-uri, la fel cum terţele părţi nu pot accesa cookie-urile deţinute de respectivul website. De exemplu, când utilizatorul distribuie un articol folosind butonul pentru reţelele sociale aflat pe un website, acea reţea socială va înregistra activitatea utiliatorului, nu website-ul pe care se află butonul.
Ce tip de informaţii sunt stocate şi accesate prin intermediul cookie-urilor?
Cookie-urile păstrează informaţii într-un fişier text de mici dimensiuni, care permit unui website să recunoască un browser. Web-serverul va recunoaşte browserul, până când cookie-ul expiră sau este şters. Cookie-ul stochează informaţii importante, care îmbunătăţesc experienţa de navigare pe Internet, de exemplu:
-
setările limbii în care se doreşte accesarea unui site;
-
păstrarea unui utilizator logat în contul de webmail;
-
securitatea online banking;
-
păstrarea produselor în coşul de cumpărături.
De ce sunt cookie-urile importante pentru Internet?
Cookie-urile reprezintă punctul central al funcţionării eficiente a Internetului, ajutând la generarea unei experienţe de navigare prietenoase şi adaptată preferinţelor şi intereselor fiecărui utilizator.Refuzarea sau dezactivarea cookie-urilor poate face unele website-uri imposibil de folosit. Refuzarea sau dezactivarea cookie-urilor nu înseamna că utilizatorul nu va mai primi publicitate online – ci doar că aceasta nu va mai putea ţine cont de preferinţele şi interesele utilizatorului, evidenţiate prin comportamentul de navigare.
Exemple de întrebuinţări importante ale cookie-urilor (care nu necesită autentificarea unui utilizator prin intermediul unui cont):
-
conţinut şi servicii adaptate preferinţelor utilizatorului – categorii de ştiri, vreme, sport, hărţi, servicii publice şi guvernamentale, website-uri distractive şi servicii de turism;
-
oferte adaptate pe interesele utilizatorilor – reţinerea parolelor, preferinţelor de limbă (ex.: afişarea rezultatelor căutărilor în limba română)
-
reţinerea filtrelor de protecţie a copiilor privind conţinutul pe Internet (opţiuni family mode, funcţii de safe search);
-
măsurarea, optimizarea şi caracteristicile de analytics – cum ar fi: confirmarea unui anumit nivel de trafic pe un website, ce tip de conţinut este vizualizat şi modul cum un utilizator ajunge pe un website (ex. prin motoare de căutare, direct, din alte website-uri etc.). Deţinătorii website-urilor derulează aceste analize pentru a perfecţiona website-urile, în beneficiul utilizatorilor.
Securitate si probleme legate de confidenţialitate
Cookie-urile NU sunt viruşi! Ele folosesc formate tip plain text. Nu sunt alcătuite din bucăţi de cod, aşa că nu pot fi executate, nici nu pot rula în mod automat. În consecinţă, nu se pot duplica sau replica pe alte reţele pentru a rula sau a se replica din nou. Deoarece nu pot îndeplini aceste funcţii, nu pot fi considerate viruşi. Cookie-urile pot fi, totuşi, folosite pentru scopuri negative. Deoarece stochează informaţii despre preferinţele şi istoricul de navigare al utilizatorilor, atât pe un anume website cât şi pe alte website-uri, cookie-urile pot fi folosite ca o formă de Spyware. Multe produse anti-spyware sunt conştiente de acest fapt şi, în mod constant, marchează cookie-urile pentru a fi şterse, în cadrul procedurilor de ştergere/scanare anti-virus/anti-spyware. În general, browserele au integrate reglaje de confidenţialitate, care furnizează diferite nivele de acceptare a cookie-urilor, perioada de valabilitate şi ştergere automată după ce utilizatorul a vizitat un anumit site.
Alte aspecte de securitate legate de cookie-uri
Deoarece protecţia identităţii este foarte valoroasă şi reprezintă dreptul fiecărui utilizator de Internet, este indicat să se ştie ce eventuale probleme pot crea cookie-urile.
Pentru că prin intermediul lor se transmit în mod constant, în ambele sensuri, informaţii între browser şi website, dacă un atacator sau persoană neautorizată intervine în parcursul de transmitere a datelor, informaţiile conţinute de cookie pot fi interceptate. Deşi foarte rar, acest lucru se poate întâmpla dacă browserul se conectează la server folosind o reţea necriptată (ex.: o reţea WiFi nesecurizată).
Alte atacuri bazate pe cookie implică reglaje greşite ale cookie-urilor pe webservere. Dacă un website nu solicită browserului să folosească doar canale criptate, atacatorii pot folosi aceasta vulnerabilitate pentru a păcăli browserele în a trimite informaţii prin intermediul canalelor nesecurizate. Atacatorii utilizează apoi informaţiile cu scopul de a accesa neautorizat anumite site-uri.
Este foarte important ca utilizatorii să fie atenţi în alegerea metodei celei mai potrivite de protecţie a informaţiilor personale.
Sfaturi pentru o navigare sigură şi responsabilă, bazată pe cookies
Datorită flexibilităţii lor şi a faptului că majoritatea dintre cele mai vizitate website-uri, inclusiv cele mai mari, folosesc cookie-uri, acestea sunt aproape inevitabile. Dezactivarea cookie-urilor nu va permite accesul utilizatorului pe site-urile cele mai răspândite şi utilizate, printre care: Facebook, Twitter, YouTube, Gmail, Yahoo şi altele.
Iată câteva sfaturi care vă pot asigura că navigaţi fără grijă, însă cu ajutorul cookie-urilor:
-
particularizaţi-vă reglajele browserului, în ceea ce priveşte cookie-urile, pentru a reflecta un nivel confortabil pentru dumneavoastră al securităţii utilizării cookie-urilor;
-
dacă nu vă deranjează cookie-urile şi sunteţi singura persoană care utilizează computerul, puteţi regla termene lungi de expirare pentru stocarea istoricului de navigare şi al datelor personale de acces;
-
dacă împărţiţi accesul la calculator, puteţi lua în considerare reglarea browserului pentru a şterge datele individuale de navigare de fiecare dată când închideţi browserul. Aceasta este o variantă de a accesa website-urile care plasează cookie-uri şi de a şterge orice informaţie de vizitare, la închiderea sesiunii de navigare;
-
instalaţi-vă şi actualizaţi-vă constant aplicaţii antispyware. Multe dintre aplicaţiile de detectare şi prevenire a spyware-ului includ detectarea atacurilor pe site-uri. Astfel, împiedică browserul de a accesa website-uri care ar putea să exploateze vulnerabilităţile browserului sau să descarce software periculos;
-
asiguraţi-vă că aveţi browserul mereu actualizat. Multe dintre atacurile bazate pe cookies se realizează exploatând punctele slabe ale versiunilor vechi ale browserelor.
Cookie-urile sunt pretutindeni şi nu pot fi evitate, dacă doriţi să vă bucuraţi de acces pe cele mai bune şi cele mai mari site-uri de pe Internet – locale sau internaţionale. Cu o înţelegere clară a modului lor de operare şi a beneficiilor pe care le aduc, puteţi lua măsurile necesare de securitate, astel încât să puteţi naviga cu încredere pe Internet.
Cum procedați dacă nu doriți să fie instalate module cookie pe computerul dumneavoastră?
Există persoane pentru care stocarea unor informații extrase din computerul sau dispozitivul lor mobil are un caracter relativ invaziv, mai ales atunci când informațiile în cauză sunt stocate și utilizate de către terți care le sunt necunoscuți. Dacă preferați, aveți posibilitatea de a bloca toate modulele cookie sau doar pe unele dintre acestea ori chiar de a elimina module cookie care au fost instalate pe terminalul dumneavoastră. Fiți însă conștient de faptul că riscați să nu puteți utiliza anumite funcții. Pentru a activa acest blocaj, trebuie să modificați parametrii de confidențialitate ai browserului. Unii operatori terți au elaborat instrumente ale căror module permit să se dezactiveze culegerea și utilizarea datelor. Dezactivarea şi refuzul de a primi cookie-uri pot face anumite site-uri impracticabile sau dificil de vizitat şi folosit. De asemenea, refuzul de a accepta cookie-uri nu înseamnă că utilizatorul nu va mai primi / vedea publicitate online. Este posibilă reglarea din browser pentru ca aceste cookie-uri să nu mai fie acceptate, sau se poate regla browserul să accepte cookie-uri de la un anumit website. Dar, de exemplu, daca un utilizator nu este înregistat folosind cookie-urile, nu va putea lăsa comentarii. Toate browserele moderne oferă posibilitatea de a schimba reglajele cookie-urilor.
Aceste reglaje se găsesc, de regulă, în meniurile (butoanele) „Opţiuni”, „Reglaje” sau „Preferinţe” ale browserului.